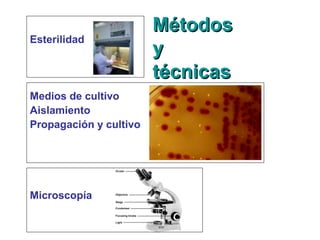
MétodosMétodos
yy
técnicastécnicas
Esterilidad
Medios de cultivo
Aislamiento
Propagación y cultivo
Microscopía
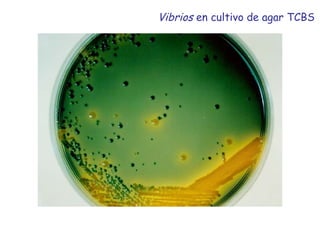
Vibrios en cultivo de agar TCBS

El documento presenta una breve historia de la microbiología desde el descubrimiento de los microorganismos hasta el desarrollo de técnicas como la filogenia molecular. Incluye hitos como las observaciones de van Leeuwenhoek, los experimentos de Pasteur y Koch que demostraron que los microorganismos causan enfermedades, el desarrollo de vacunas, y la clasificación de microorganismos mediante análisis filogenético del ARN ribosomal. También describe diversidad y filos de bacterias y archaeas hipertermófilas.